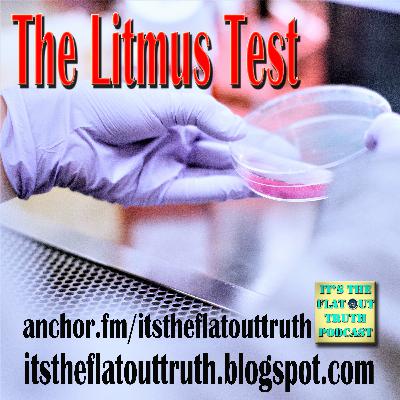
The Litmus Test

What in the World?
Update: 2020-05-24
Description
Are you empowered? Are you a freethinker or do you think what you are programmed and told to think? As a man thinks so he is. Are we freemen or are we willing slaves to a system that wants to control every aspect of our being every aspect of our lives? As it stands in the present, you can go shopping but you can only buy what we tell you to buy.
Comments
In Channel